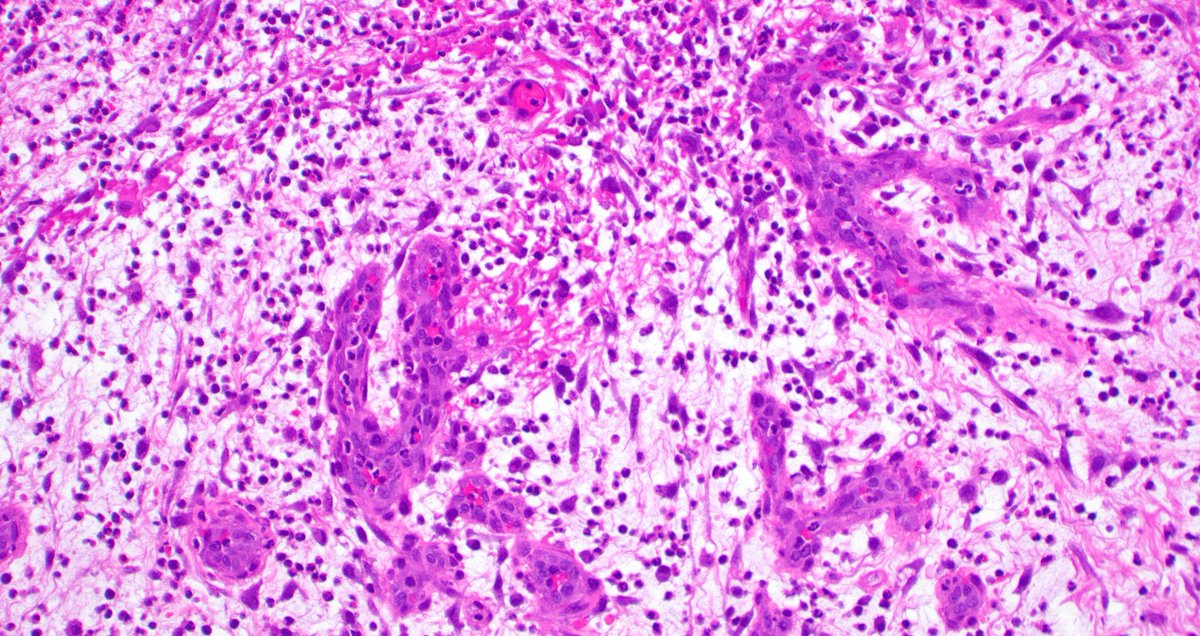
mreyesm's tweet image. &quot;Granulation tissue&quot; is called like that because it forms small granules due to new vessel formation during the wound healing repair. Under the microscope, it looks like what you see in these pictures. #Pathology #GranulationTissue

Shruberry, MD
@pathunderdoc
baby Pathologist trained at Bombay Hospital, Mumbai #pathtwitter
Dit vind je misschien leuk
Illustration of Different Tumor Types Based on Cytologic Patterns 🔬 eclinpath.com/cytology/cytol…


Very pretty watercolor pictures made by the resident.


I often feel bad for the child of senior citizen patients who accompanies them to the clinic for their appointments/checkups and yet all that the senior citizen patients want to talk about or praise is their other child who is settled abroad but is never with them in sickness.
Microgranular #APL: large blasts with paucity/absence of granules & many bilobed nuclei. This case has unusual immunophenotype by flow: NEG CD117, partial positivity for HLA-DR, dim CD2. Blasts were neg for CD34 and showed bright MPO. #Hemepath #Acute #promyelocytic #leukemia

🐅 Tigroid Background 💉 Seen in FNA, Diff-Quik stains 🔬 In Tumors w ⬆️ Glycogen; Cytoplasmic Fragility; +/- Clear Cell morphology Examples: Seminoma, Ewing's, Parathyroid adenoma, Clear cell Sarcoma, Squamous cell carcinoma (clear cell variant). #pathx #cytopath #pathology


If B cell lymphomas had a calendar today 📆 … 05/05/20 25 😉 a #hemepath #CincoDeMayo #MetGala post 📍CLL (CD5) 📍Mantle cell lymphoma (CD5) 📍DLBCL (CD20) 📍Hairy cell leukemia (CD25) #Nerdy…. I admit 🤓 even for a pathologist! 🙈 #IYKYK

Promyelocytes are one step more mature than Myeloblasts. So naturally they will shed early stem cell defining antigens like CD34 and HLA DR. So APL should be CD34 negative and HLA DR negative. Other clue: Usually comes to ED with DIC on a Friday evening.
"Multinucleated giant histiocytes" are not rare in FNAs of Papillary Thyroid Carcinoma and should not be overinterpreted as pleomorphic tumor giant cells.

✈️ In flight emergencies 🚨What to do if you are called upon to attend a medical emergency midflight❓️


Focal Active Colitis My staff likes to call it the "pimple" of the colon in ADULTS -- (eg. it's common, nonspecific) In CHILDREN, however, ~25% are later found to have Crohn's, so be on the look 👀 out in kids! #pathx #gipath #crohns #colitis

"Granulation tissue" is called like that because it forms small granules due to new vessel formation during the wound healing repair. Under the microscope, it looks like what you see in these pictures. #Pathology #GranulationTissue

More people lose from fear of failure than actual failure.
"NEVER forget the path of the traversing FNA needle". Liver mass in a 50/M with history of "Pancreatic Neuroendocrine Tumor (PanNET)". The flat sheets of mesothelial cells present a beautiful and eye-catching contrast with the background metastatic PanNET.




Mesothelial cell : tips and tricks for cytology of effusions. #cytopath #PathBoards




"Wiry vessels and sticky hepatocytes". Well-differentiated "Hepatocellular Carcinoma", (Liver, FNA)

Medicine is full of exceptions #thyroid tumor with nuclear inclusions is not always PTC Ki-67 can be a membrane marker too HYALINIZING TRABECULAR TUMOR 🎈 #path #pathology #cancer #endocrine


United States Trends
- 1. #BaddiesUSA 55.5K posts
- 2. Rams 28.6K posts
- 3. Scotty 9,376 posts
- 4. #TROLLBOY 1,822 posts
- 5. Chip Kelly 8,276 posts
- 6. Cowboys 99K posts
- 7. Eagles 139K posts
- 8. Stafford 14.5K posts
- 9. Raiders 66.4K posts
- 10. Bucs 12.1K posts
- 11. Baker 20.7K posts
- 12. #RHOP 11.3K posts
- 13. #ITWelcomeToDerry 14.4K posts
- 14. Stacey 27.9K posts
- 15. #LAShortnSweet 16.4K posts
- 16. Ahna 6,568 posts
- 17. Teddy Bridgewater 1,190 posts
- 18. Todd Bowles 1,999 posts
- 19. DOGE 162K posts
- 20. Vin Diesel 1,082 posts
Something went wrong.
Something went wrong.



























































































































